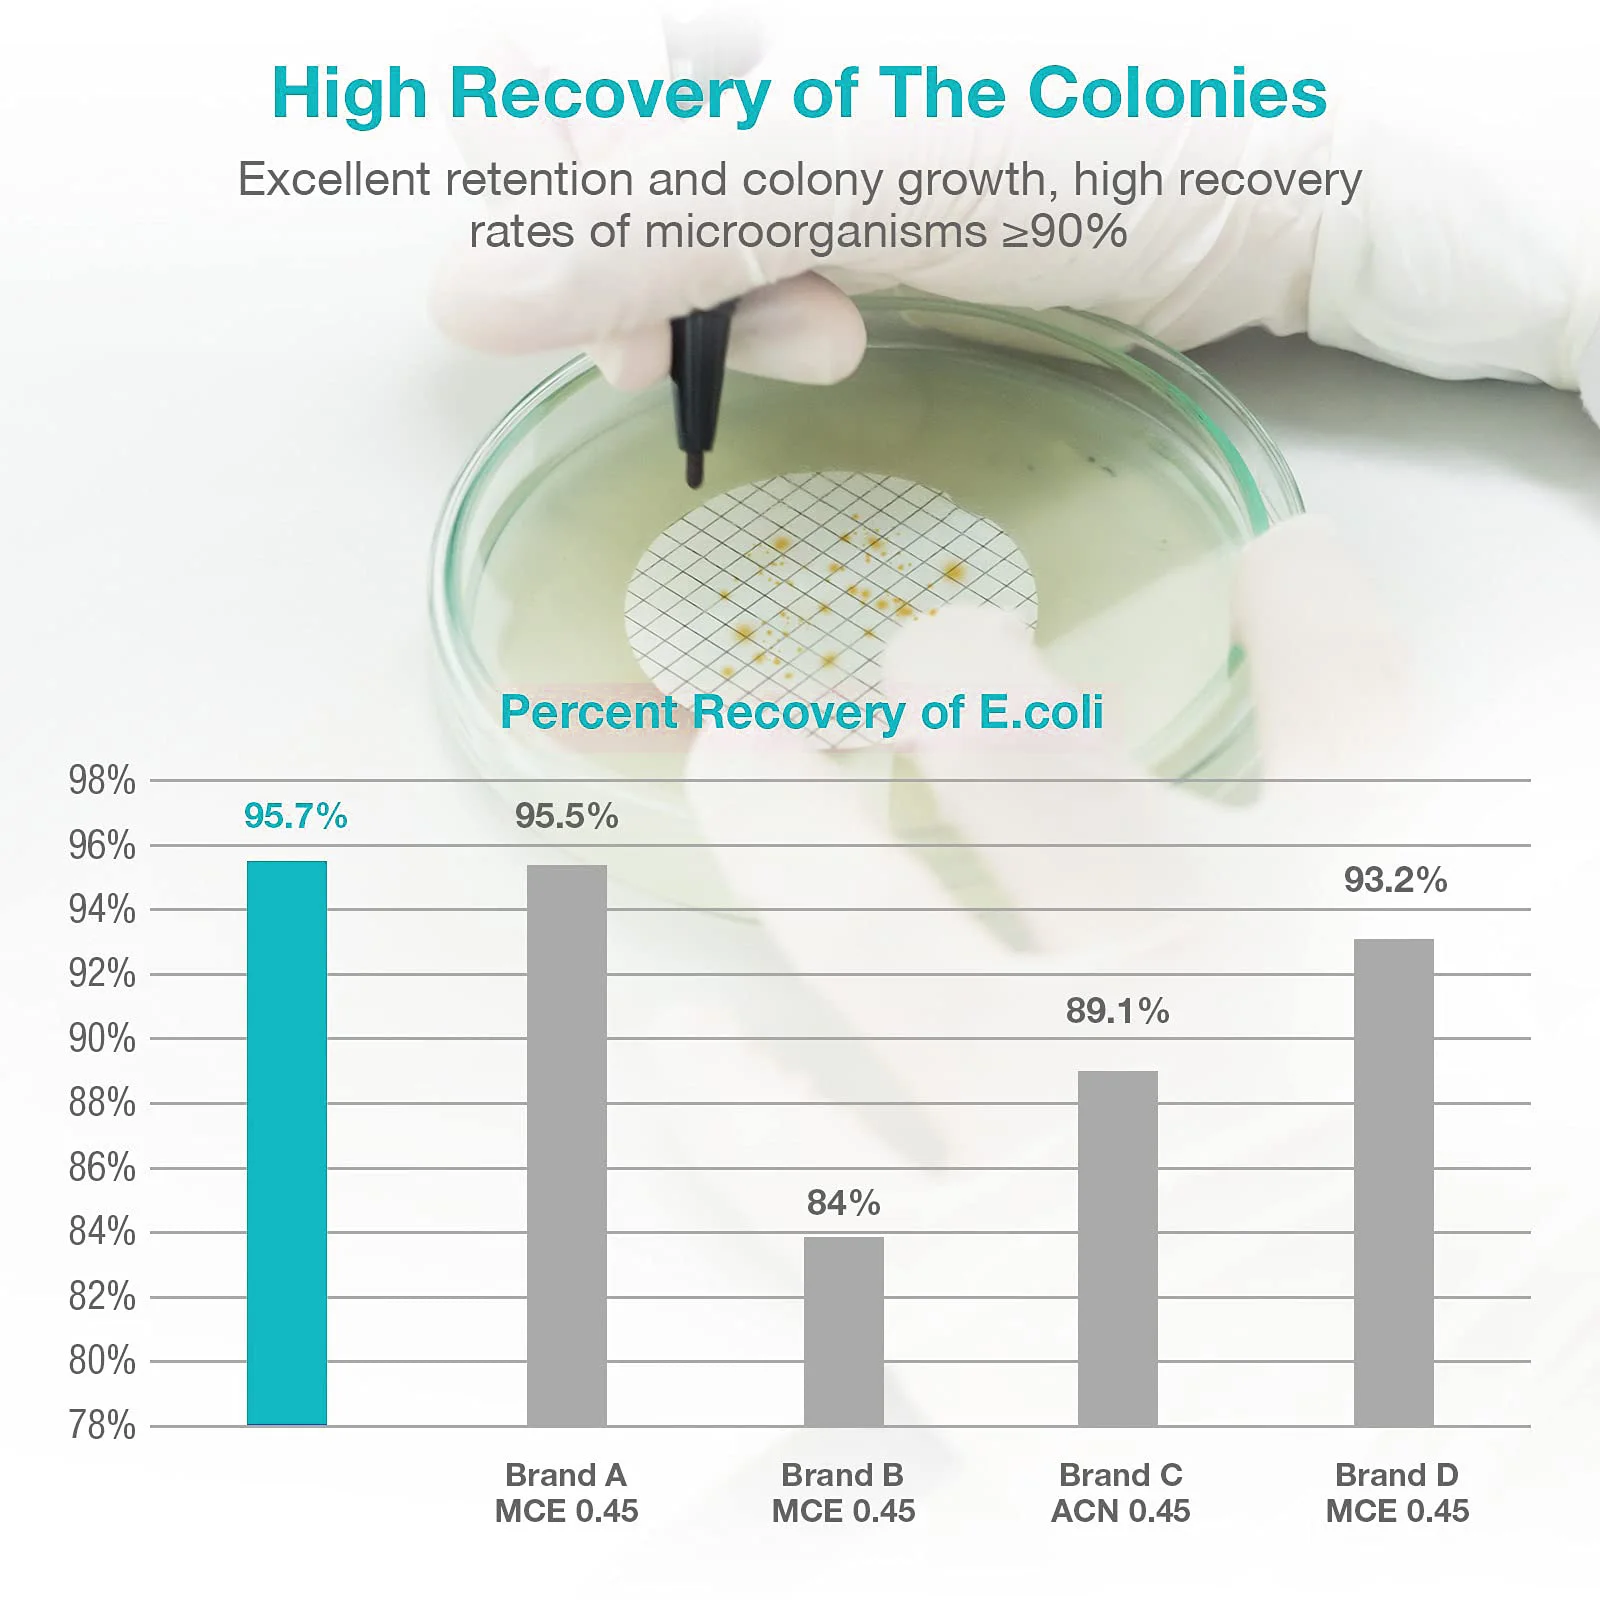
thumb

SELTON Стерильные мембранные фильтры MCE 0,45 мкм 47 мм 25 шт.
Price history chart & currency exchange rate
Customers also viewed

$197.82
8 X 6FT Outdoor Storage Shed Patio Grey Metal Shed With Sliding Door Garden Storage With Pent Roof Lawn Sheds Waterproof House
aliexpress.com
$13.72
ABKO-Crankshaft Crank Shaft Fit For STIHL MS 021 023 MS230 025 MS250 MS210 MS 230 Garden Tools Chainsaw Parts 1123 030 0400
aliexpress.com
$2.99
Стоматологический держатель для ватных рулонов, клипса из нержавеющей стали и хлопка для ватных рулонов, увлажняющий зажим, молярный предмолярный стоматологический клиник, Орто изолятор, инструменты, 4 шт.
aliexpress.ru
$16.78
1,5 мм горелка на отработанном масле насадка, распылитель воздуха, мазут, сопла, полный конус нефтяные форсунки
aliexpress.ru
$239.13
Для BMW G650X G650GS G310GS G310R Knight рюкзак сумка для мотоциклетного шлема дорожное оборудование Водонепроницаемая большая емкость
aliexpress.ru
$2.89
24Pcs Matte Press On Fake Nails With Jelly Glue Dark Brown Artificial Short Stiletto False Nails DIY Finger Manicure Tool
aliexpress.ru
$1,784.92
Тележка из нержавеющей стали для банкетов, Тележка из нержавеющей стали для горячей еды, Мобильная тележка для банкетов, тележка для еды
aliexpress.ru
$4.13
24 Pcs Christmas Gel Pen Pens Universal Accessories Scrapbook Student Signature Writing Plastic
aliexpress.ru
$10.02
Shaving Nose Ear Trimmer Safe Face Care Rechargeable Nose Hair Trimmer for Men Shaving Hair Removal Beard
aliexpress.com
$228.72
Вытяжка Elikor AC6634W1 60 белый/дуб неокрашенный, Кухонная вытяжка Elikor AC6634W1 60 белый/дуб неокрашенный
imarket.by
$3.90
1 пара искусственных палочек, профессиональные перкуссионные инструменты, ксилофон Marimba Mallets, кленовые деревянные ручки, резиновые маллеты
aliexpress.ru
$461.23
DKC Навесной шкаф CE из нержавеющей стали (AISI 304), 1200 x 600 x 300мм, с фланцем, Серый, "RAM block" - металлические корпусные решения для автоматизации
220city.ru
$31.79
5.2'' Mobile LCD Display For Huawei Honor 6C Pro JMM-L22 LCD Display Touch Screen Digitizer Sensor Assembly Tools Protector Film
aliexpress.com
$7.86
Кара & Kale Boho модное ювелирное изделие, в готическом стиле, ожерелье-воротник Веревка браслетов, ожерелий, диаметр-& Бусы из натурального камн...
aliexpress.com
$7.00
Лидер продаж, новинка, фотомагнитола, G5V 1 G5V1 24 В постоянного тока, 24 В постоянного тока, 24 В, 6-контактный реальный
aliexpress.ru
$24.98
Winter Couples Double Sides Flannel Warm Night Dress Women Soft Coral Fleece Thick Long Bathrobe Nightgown Female Patchwork Robe
aliexpress.com
$0.73
1pcs Nib Fountain Pen Universal Other Pen You Can Use Series the Student the Tip Pen Other Replace Stationery F4C3
aliexpress.com
$32.45
Повседневные спортивные мужские модные популярные спортивные мужские ботинки; Кожаные лоферы; Кроссовки; Повседневная мужская повседневн...
aliexpress.com
$41.26
2020 new korean style harajuku backpack men's and women's casual simple backpack trendy unique student schoolbag travel bag
fordeal.com